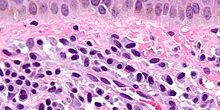
Mastocytosis_-_cropped_-_very_high_mag

پنل فلوسایتومتری برای تشخیص ماستوسیتوز (Panel for diagnosis Mastocytosis) شامل چندین نشانگر سطحی است که برای شناسایی و تمایز ماستوسیتها (نوع خاصی از سلولهای سیستم ایمنی) استفاده میشوند. ماستوسیتوز یک بیماری است که در آن تعداد زیادی ماستوسیت در بافتهای مختلف بدن تجمع مییابند. در اینجا به توضیح نشانگرهای این پنل پرداختهام:
- CD117: همچنین به عنوان c-Kit شناخته میشود، این نشانگر در سطح ماستوسیتها وجود دارد و نقش مهمی در رشد و تکثیر این سلولها دارد.
- CD45: یک پروتئین موجود بر روی سطح تمامی سلولهای سیستم ایمنی است و در شناسایی و تمایز سلولهای ایمنی از دیگر سلولها کمک میکند.
- CD33: یک نشانگر سطحی است که بیشتر بر روی سلولهای میلوئیدی (یک نوع سلول خونی) یافت میشود.
- CD68: یک پروتئین است که معمولاً در ماکروفاژها (نوعی سلول سیستم ایمنی) یافت میشود و میتواند در شناسایی برخی سلولهای خاص از جمله ماستوسیتها مفید باشد.
- CD2 و CD25: این دو نشانگر به طور مشترک برای شناسایی یک زیرگروه خاص از ماستوسیتها که ممکن است در ماستوسیتوز نقش داشته باشند، استفاده میشوند. حضور هر دوی این نشانگرها بر روی ماستوسیتها میتواند نشاندهنده وجود ماستوسیتوز باشد.
فلوسایتومتری با استفاده از آنتیبادیهای فلورسنتی که به این نشانگرها متصل میشوند، امکان شناسایی و تحلیل دقیق ماستوسیتها را فراهم میکند. این روش به پزشکان کمک میکند تا به درک بهتری از توزیع و خصوصیات ماستوسیتها در بدن بیمار دست یابند و در تشخیص ماستوسیتوز موثر باشد.
آزمایشگاه چکاپ به عنوان آزمایشگاه تخصصی خون شناسی در کرج، ارائه کننده خدمات تخصصی فلوسایتومتری به مراجعین عزیز میباشد.